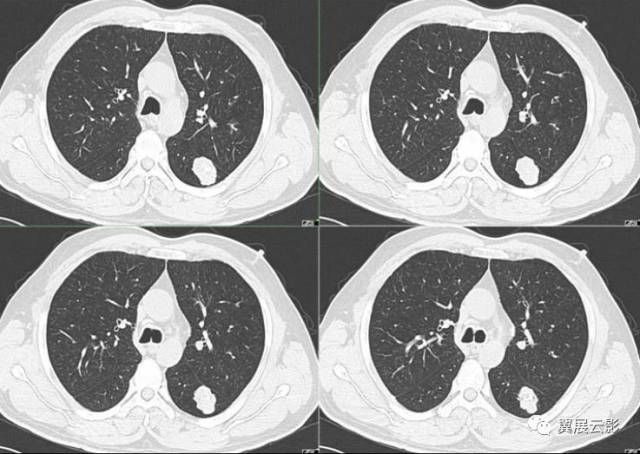
8种肺部良性肿瘤及肿瘤样病变
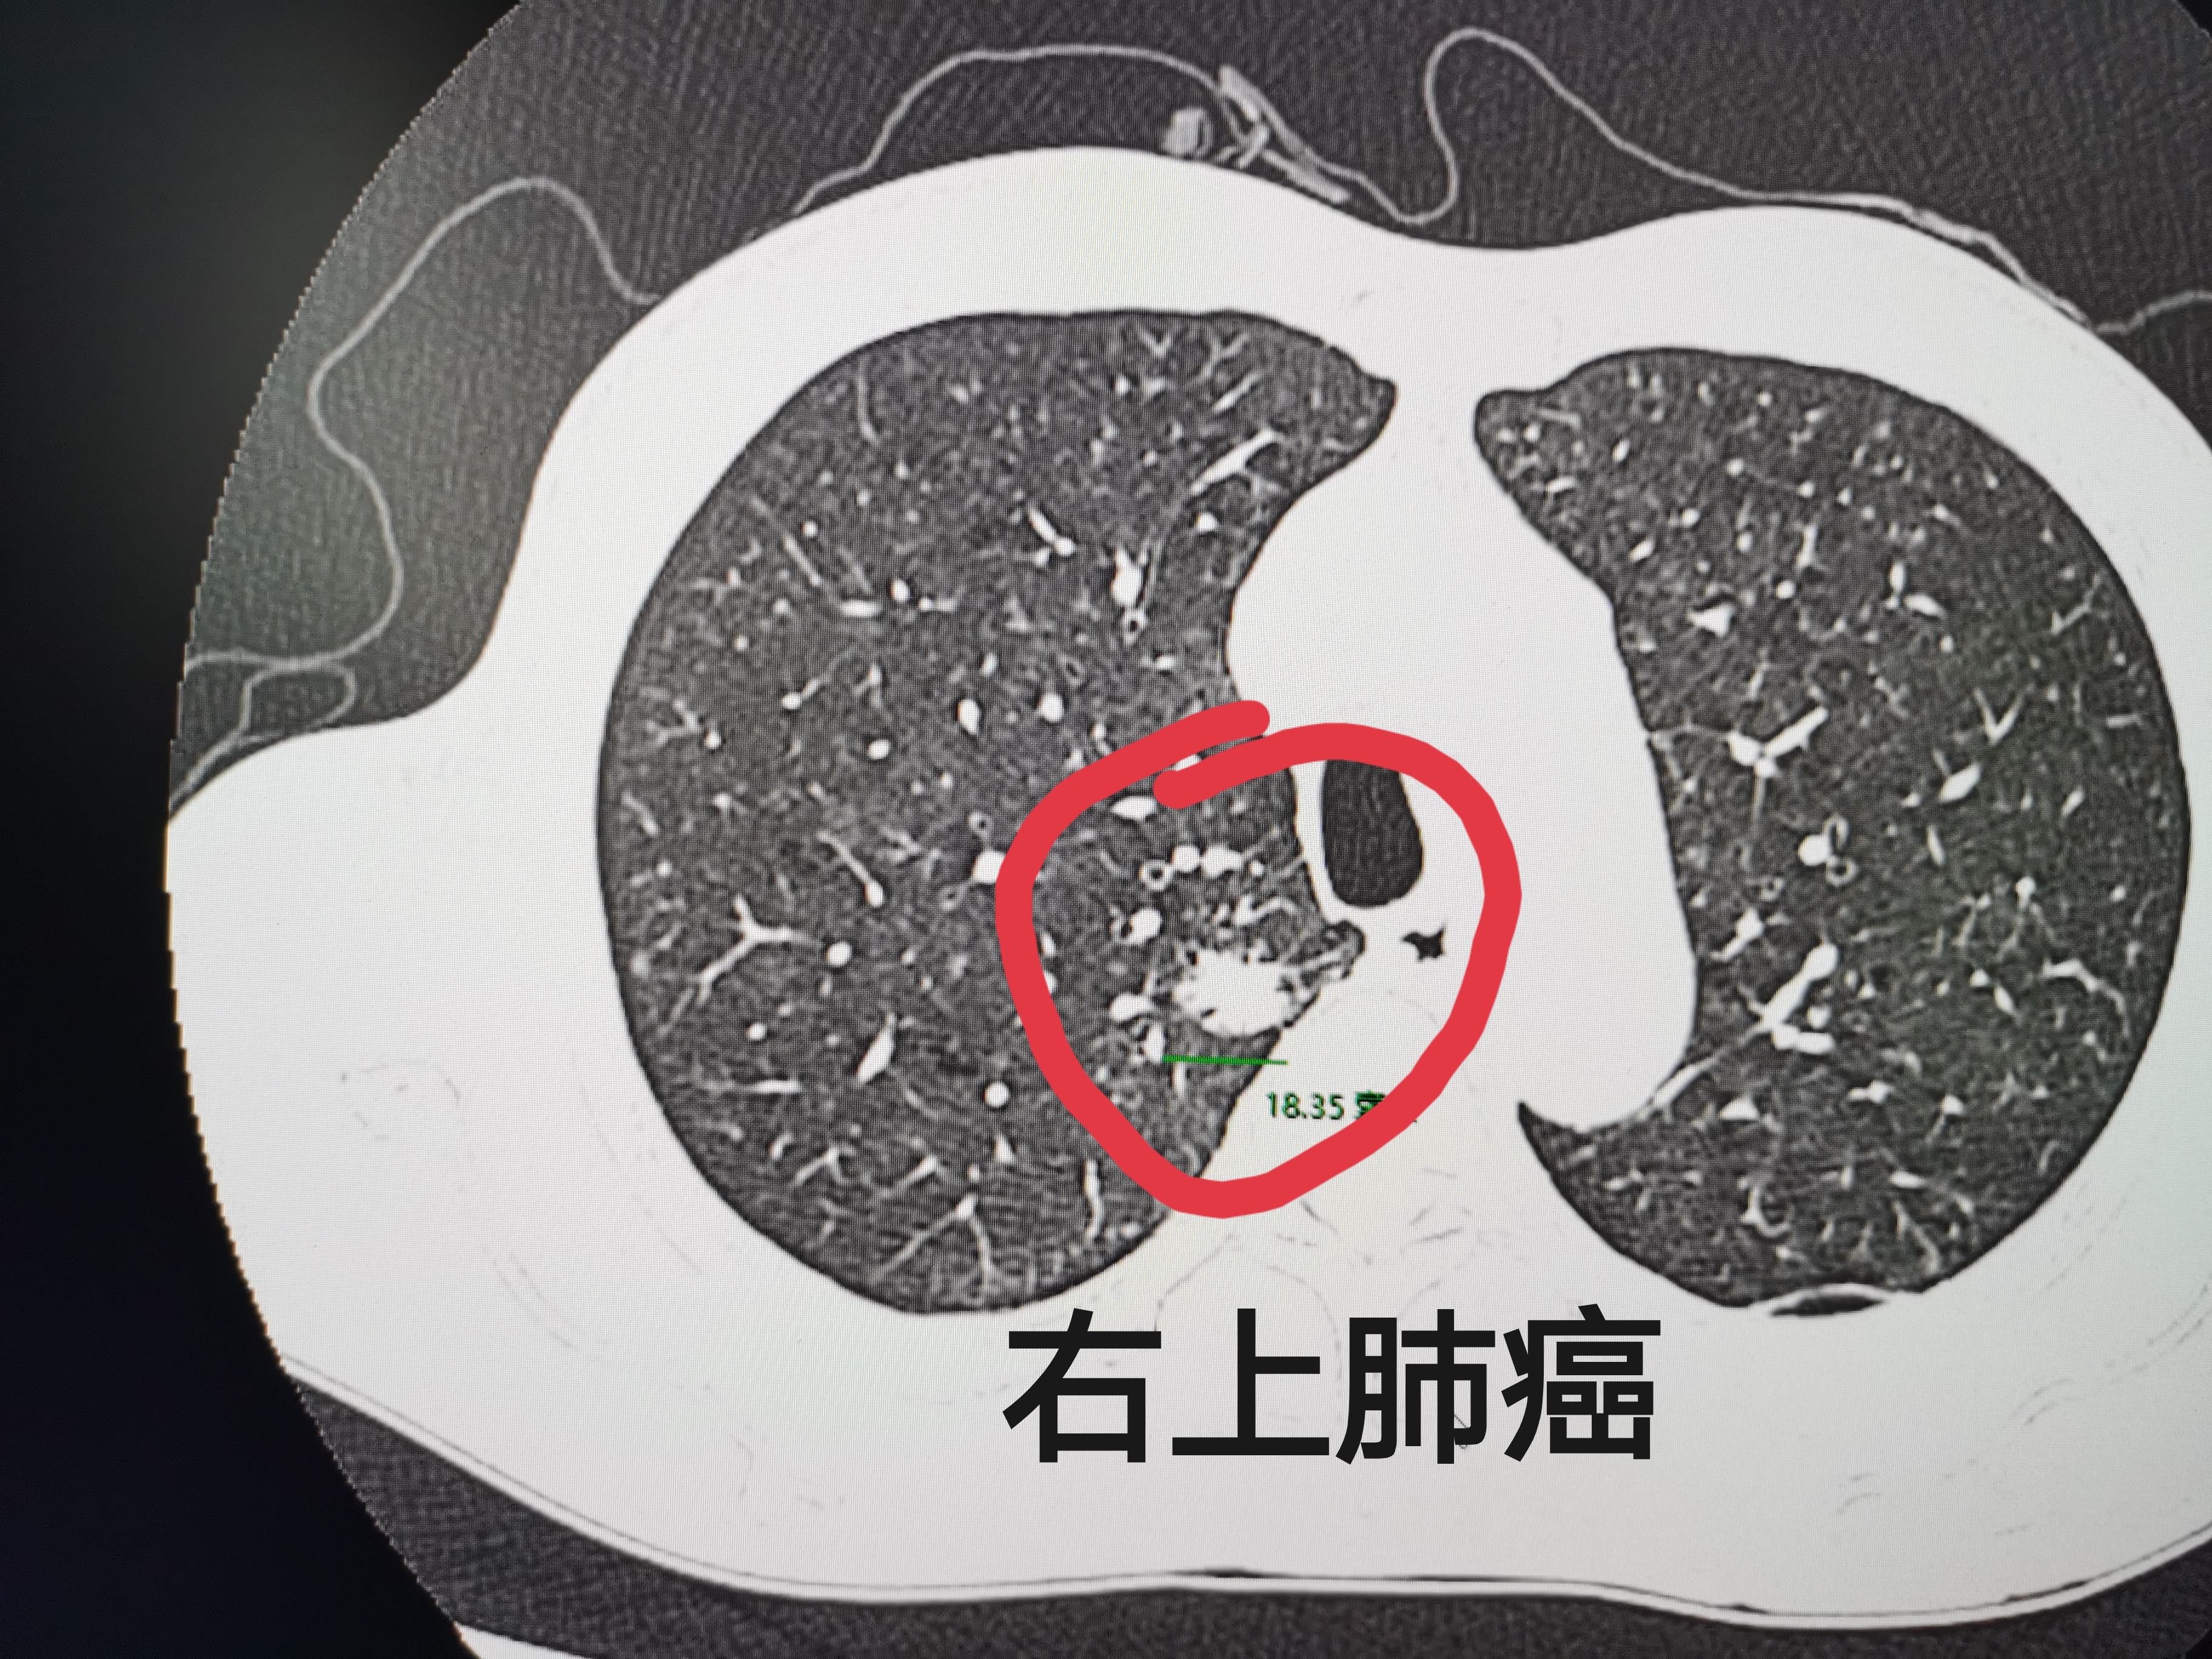
出车祸断了四根肋骨,却因此救回一命,不是开玩笑吧?

肺癌良性

建华肿瘤一科微创治疗肺癌病例分享
图片尺寸4032x3024
刘懿博士说肺癌二五九〇切之前知道俩肺结节是良性但不是一种病
图片尺寸1354x1006
肺良性肿瘤
图片尺寸1080x2160
刘懿博士说肺癌二五九〇切之前知道俩肺结节是良性但不是一种病
图片尺寸1354x913
刘懿博士说肺癌(三〇八亖)肺良性占位长大也会咯血,要及时切掉
图片尺寸1600x1227
肺部良性肿瘤及肿瘤样病例
图片尺寸773x1014
肺部良性肿瘤及肿瘤样病例
图片尺寸821x686
肺良性肿瘤影像表现
图片尺寸797x642
8种肺部良性肿瘤及肿瘤样病变
图片尺寸640x454
肺良性肿瘤影像表现
图片尺寸1080x780
最常见的肺良性肿瘤…_肺肿瘤_肺肿瘤介绍 - 好大夫在线
图片尺寸1145x788
肺良性肿瘤影像表现
图片尺寸932x651
出车祸断了四根肋骨,却因此救回一命,不是开玩笑吧?
图片尺寸3648x2736
肺良性肿瘤影像表现
图片尺寸861x661
肺良性肿瘤
图片尺寸960x720
提示:根据患者的临床病史和影像特征,您的诊断是()
图片尺寸561x643
肺良性肿瘤影像表现
图片尺寸1080x792
胸部良性肿瘤样变大盘点
图片尺寸640x476
肺良性肿瘤影像表现
图片尺寸1080x727
",其形状为圆形,比正常肺实质更致密,肺部结节可能是早期肺癌的征兆
图片尺寸640x687